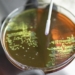

New Delhi: Cricket Australia on Friday confirmed that the ongoing BBL 15 will receive an influx of talent, with multiple members of Australia’s Ashes-winning Test squad returning to action starting Saturday.
Among those returning to play in BBL 15 for various teams are Alex Carey with the Adelaide Strikers; Brendan Doggett with the Melbourne Renegades; Josh Inglis with the Perth Scorchers; Usman Khawaja and Marnus Labuschagne with the Brisbane Heat; Todd Murphy and Steve Smith with the Sydney Sixers; and Jake Weatherald and Beau Webster with the Hobart Hurricanes. All will be eligible for selection starting January 10.
Michael Neser will join the Brisbane Heat on January 14, while Mitchell Starc will rejoin the Sydney Sixers on January 16.
Conversely, three players will not be returning for the remainder of the BBL 15 season. Scott Boland and Travis Head will be sidelined for an extended period to recover after playing in all five Ashes Test matches. Cameron Green is also unavailable at this time as he continues his recovery from back surgery.
Throughout the series, Boland had a heavy workload, bowling a total of 159.5 overs, while Head finished as Australia’s top run-scorer in the Ashes.
Cricket Australia (CA) indicated that all players who participated in the Ashes will follow individual treatment plans to allow for proper recovery while also preparing for their next international commitments, including the 2024 ICC T20 World Cup. CA also intends for the Ashes players to participate in the BBL as much as possible.
“The BBL 15 season has delivered outstanding cricket and incredible fan experiences, watched by record crowds and broadcast audiences so far,” said Alistair Dobson, Cricket Australia’s Executive General Manager, Big Bash Leagues.
“We are delighted to have a number of Australian Test players entering the competition from tomorrow night, following their Ashes series victory, and thank them for their commitment to the BBL.”
Cricket Australia’s General Manager, National Teams, Ben Oliver, added, “We are immensely proud of the Australian men’s Test team and their outstanding achievement in winning the Ashes. A five-Test Ashes series is intense. The players and staff deserve great credit for their preparation and management, which has enabled sustained performance through a demanding international schedule.
“We have worked with each player on individual plans to best support recovery from the Ashes and preparation for upcoming international commitments, including the ICC T20 World Cup. Wherever possible, this includes players representing their clubs in the ongoing BBL 15 season over the coming fortnight.”
(IANS)